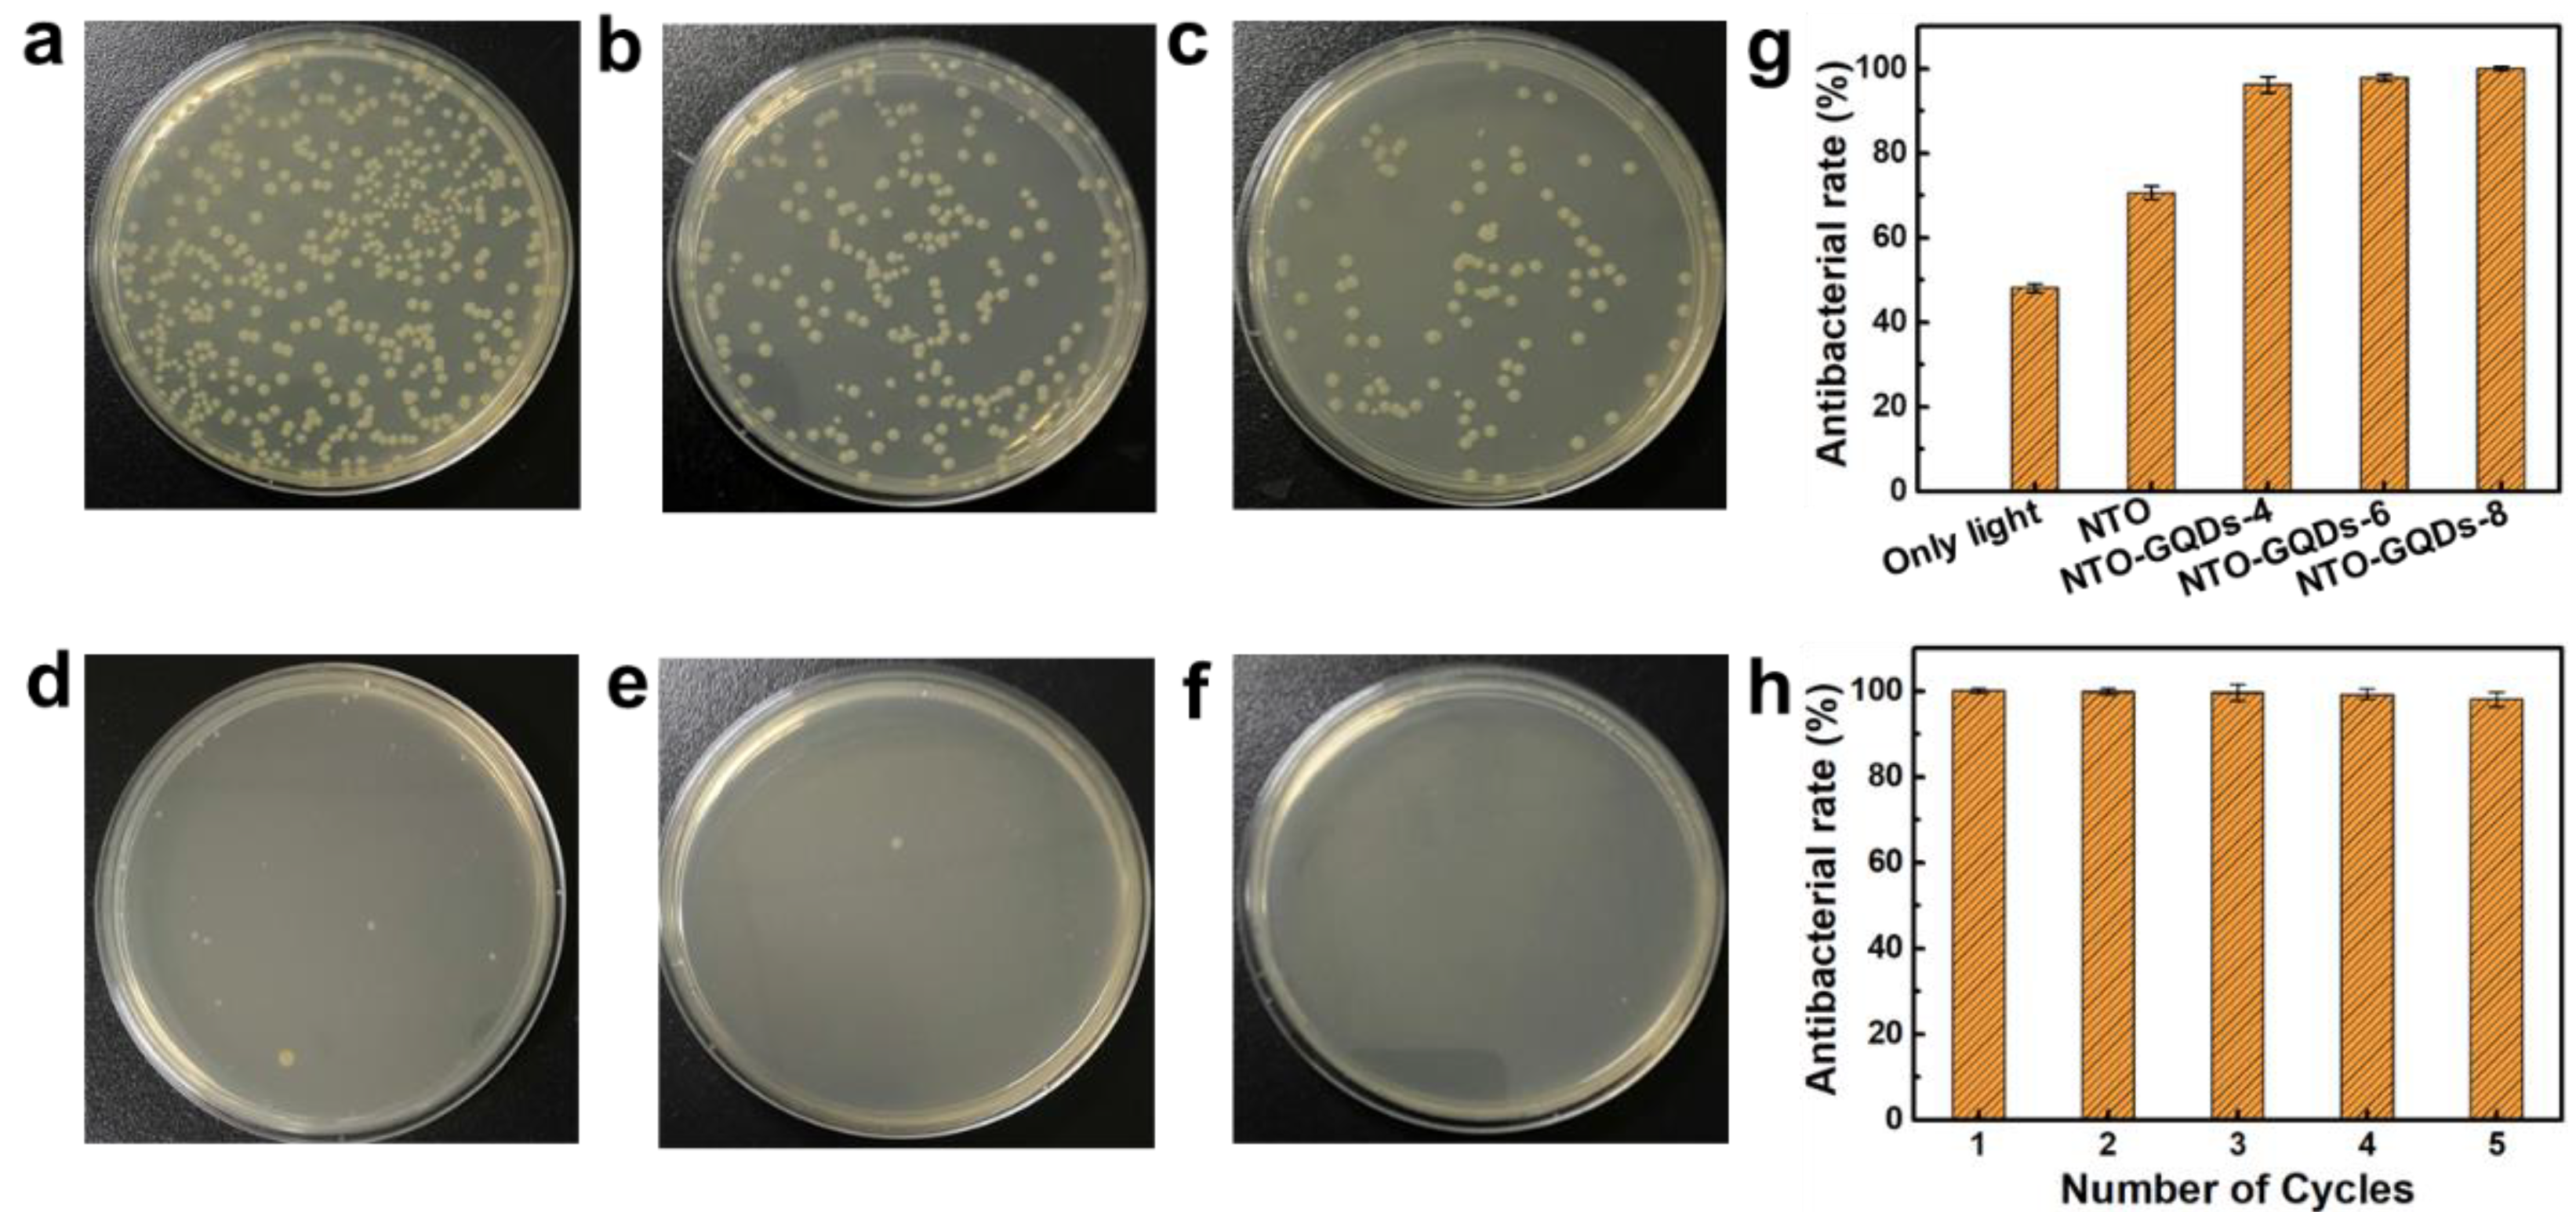
Materials 18 01844 g004
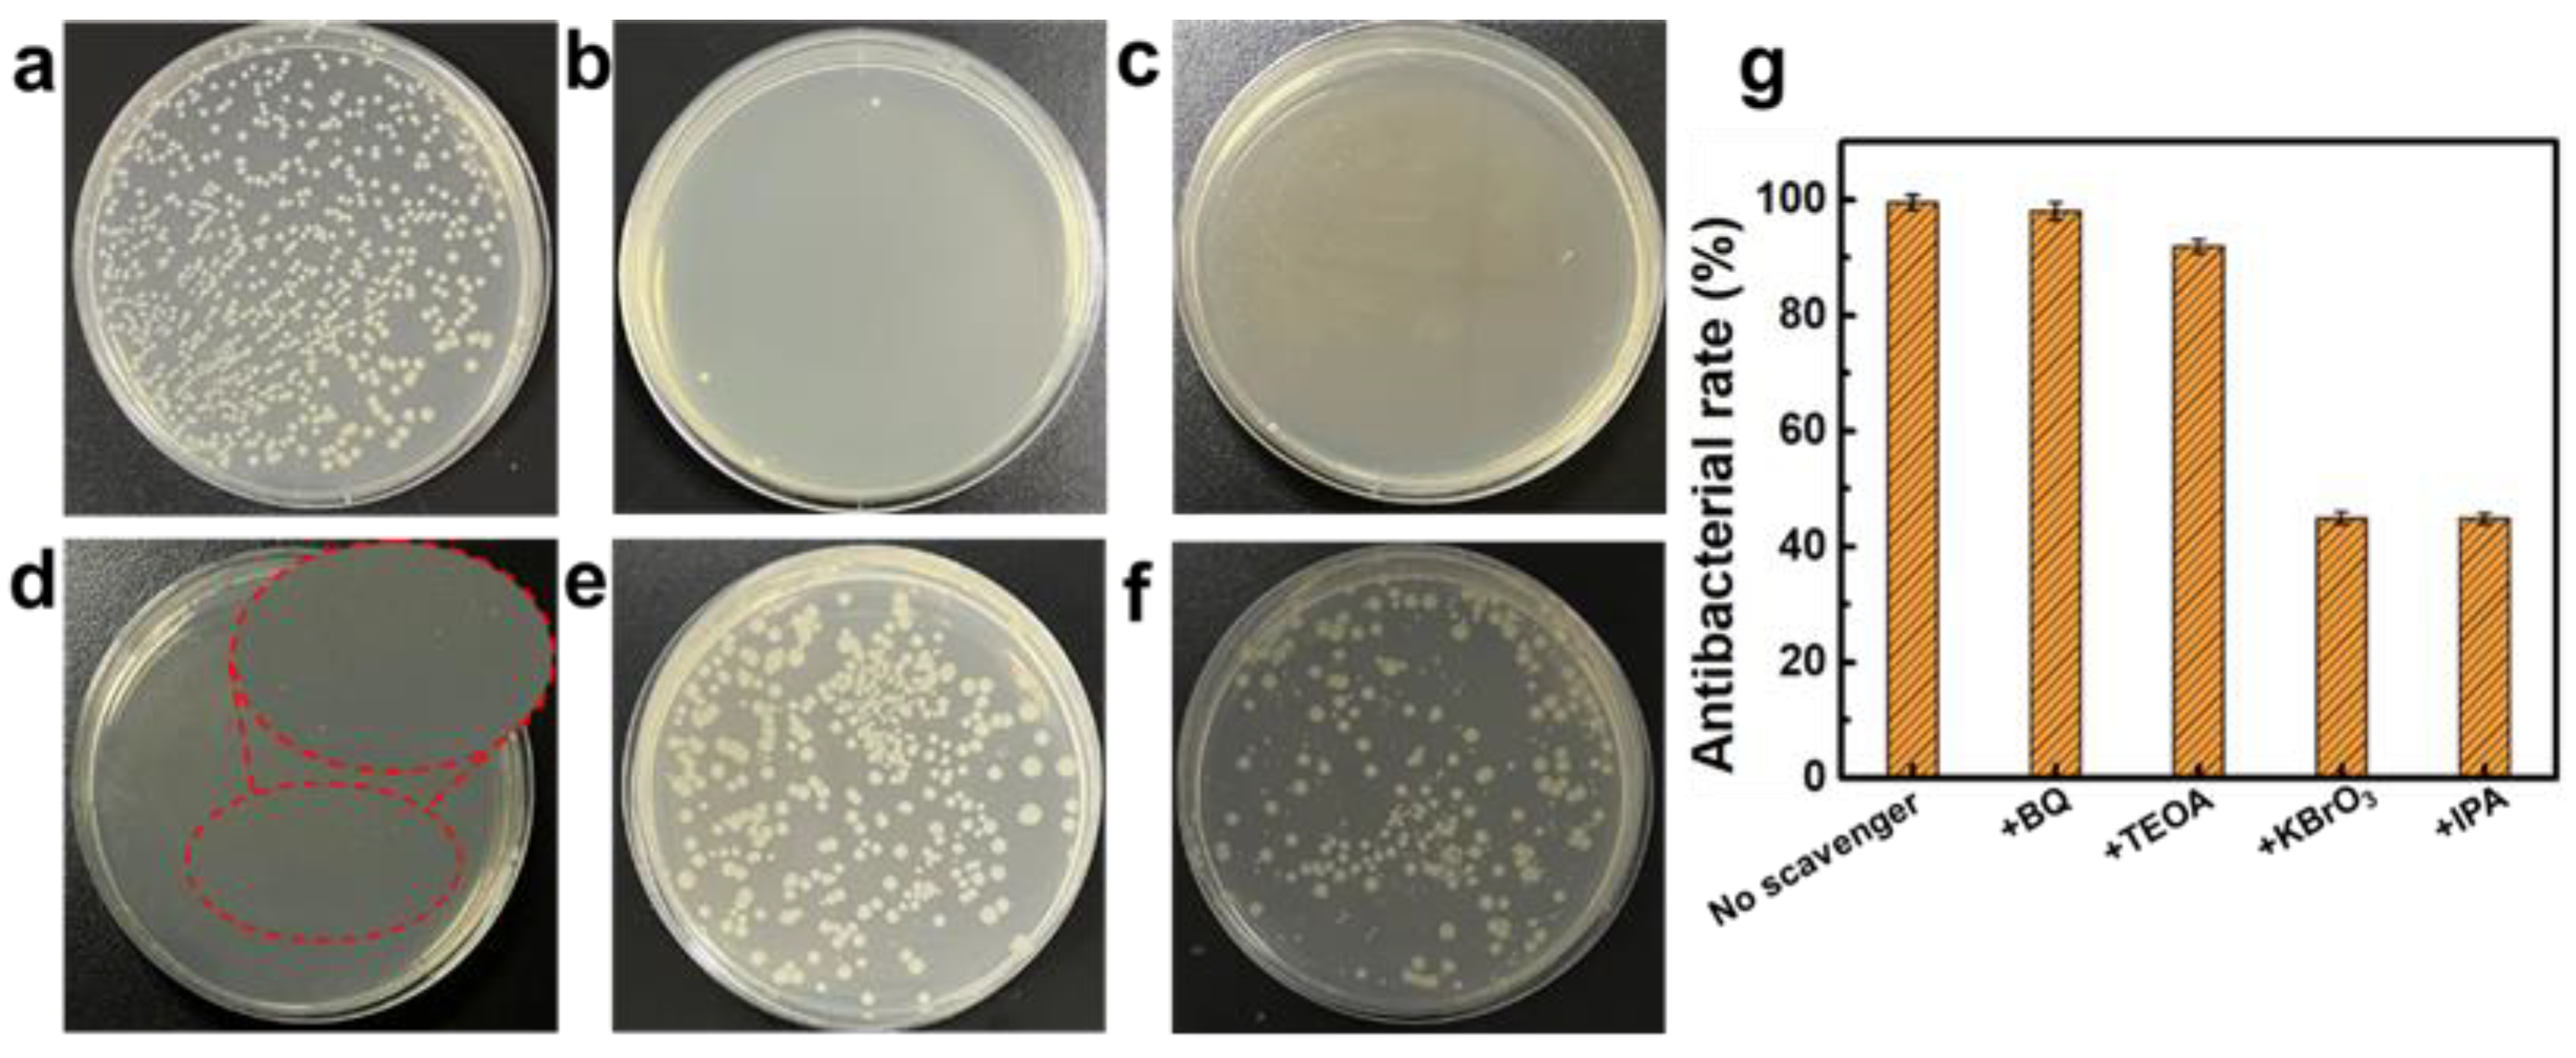
Materials 18 01844 g005

Enhanced Antibacterial Activity of Sodium Titanate/Graphene Quantum Dot Self-Supporting Membranes via Synergistic Photocatalysis and Physical Cutting
Abstract
1. Introduction
2. Materials and Methods
2.1. Materials
2.2. Preparation of GQDs
2.3. Preparation of NTO/GQDs
2.4. Preparation of NTO/GQD Self-Supporting Membranes
2.5. Characterization
2.6. Photocatalytic Antibacterial Test of NTO/GQD Self-Supporting Membranes
3. Results and Discussion
4. Conclusions
Supplementary Materials
Author Contributions
Funding
Institutional Review Board Statement
Informed Consent Statement
Data Availability Statement
Conflicts of Interest
References
- Ran, B.; Ran, L.; Wang, Z.; Liao, J.; Li, D.; Chen, K.; Cai, W.; Hou, J.; Peng, X. Photocatalytic Antimicrobials: Principles, Design Strategies, and Applications. Chem. Rev. 2023, 123, 12371–12430. [Google Scholar] [CrossRef] [PubMed]
- She, P.; Li, S.; Li, X.; Rao, H.; Men, X.; Qin, J.S. Photocatalytic Antibacterial Agents Based on Inorganic Semiconductor Nanomaterials: A Review. Nanoscale 2024, 16, 4961–4973. [Google Scholar] [CrossRef]
- Zhou, Z.; Li, B.; Liu, X.; Li, Z.; Wu, S. Recent Progress in Photocatalytic Antibacterial. ACS Appl. Bio Mater. 2021, 4, 3909–3936. [Google Scholar] [CrossRef]
- Chang, Y.C.; Lin, J.C.; Wu, S.H. One-Step Growth of Na2Ti3O7 Nanorods for Enhanced Photocatalytic Activities and Recyclability. J. Alloys Compd. 2018, 749, 955–960. [Google Scholar] [CrossRef]
- Li, F.; Du, P.; Liu, W.; Li, X.; Ji, H.; Duan, J.; Zhao, D. Hydrothermal Synthesis of Graphene-Grafted Titania/Titanate Nanosheets for Photocatalytic Degradation of 4-Chlorophenol: Solar-Light-Driven Photocatalytic Activity and Computational Chemistry Analysis. Chem. Eng. J. 2018, 331, 685–694. [Google Scholar] [CrossRef]
- Wu, Y.; Sun, Y.; Fu, W.; Meng, X.; Zhu, M.; Ramakrishna, S.; Dai, Y. Graphene-Based Modulation on the Growth of Urchin-like Na2Ti3O7 Microspheres for Photothermally Enhanced H2 Generation from Ammonia Borane. ACS Appl. Nano Mater. 2020, 3, 2713–2722. [Google Scholar] [CrossRef]
- Jiang, M.; Yang, Z.; Lu, T.; Liu, X.; Li, J.; Wang, C.; Yang, G.; Pan, L. Machine Learning Accelerated Study for Predicting the Lattice Constant and Substitution Energy of Metal-Doped Titanium Dioxide. Ceram. Int. 2024, 50, 1079–1086. [Google Scholar] [CrossRef]
- Fytory, M.; Khalid, S.A.; Zaki, A.H.; Fritzsche, W.; Azzazy, H.M.E. Photocatalytic Nanocomposite Based on Titanate Nanotubes Decorated with Plasmonic Nanoparticles for Enhanced Broad-Spectrum Antibacterial Activity. ACS Appl. Bio Mater. 2024, 7, 6720–6729. [Google Scholar] [CrossRef]
- Kusiak-Nejman, E.; Morawski, A.W. TiO2/Graphene-Based Nanocomposites for Water Treatment: A Brief Overview of Charge Carrier Transfer, Antimicrobial and Photocatalytic Performance. Appl. Catal. B Environ. 2019, 253, 179–186. [Google Scholar] [CrossRef]
- Moon, K.S.; Bae, J.M.; Choi, E.J.; Oh, S. Titania Nanotubes with Aminated Reduced Graphene Oxide as Efficient Photocatalysts for Antibacterial Application under Visible Light. Sci. Rep. 2025, 15, 6127. [Google Scholar] [CrossRef]
- Zhang, J.; Wang, W.; Huang, S.; Lv, Y.; Li, M.; Wu, M.; Wang, H. Metal-Free Photocatalyst with Reduced Graphene Oxide-Doped Graphitic Carbon Nitride Homojunctions for Efficient Antibacterial Applications. RSC Adv. 2025, 15, 2444–2451. [Google Scholar] [CrossRef] [PubMed]
- Ghaffarkhah, A.; Hosseini, E.; Kamkar, M.; Sehat, A.A.; Dordanihaghighi, S.; Allahbakhsh, A.; van der Kuur, C.; Arjmand, M. Synthesis, Applications, and Prospects of Graphene Quantum Dots: A Comprehensive Review. Small 2022, 18, 2102683. [Google Scholar] [CrossRef]
- Shen, S.; Wang, J.; Wu, Z.; Du, Z.; Tang, Z.; Yang, J. Graphene Quantum Dots with High Yield and High Quality Synthesized from Low-Cost Precursor of Aphanitic Graphite. Nanomaterials 2020, 10, 375. [Google Scholar] [CrossRef]
- Park, J.; Moon, J.; Ri, V.; Lee, S.; Kim, C.; Cairns, E.J. Nitrogen-Doped Graphene Quantum Dots: Sulfiphilic Additives for High-Performance Li-S Cells. ACS Appl. Energy Mater. 2021, 4, 3518–3525. [Google Scholar] [CrossRef]
- Mishra, S.R.; Mandal, T.; Sahu, S.; Mishra, M.; Senapati, R.N.; Singh, V. Biocompatible Fluorescent Graphene Oxide Quantum Dots for Imaging of Drosophila melanogaster. ACS Omega 2024, 9, 38916–38924. [Google Scholar] [CrossRef] [PubMed]
- Hui, L.; Huang, J.; Chen, G.; Zhu, Y.; Yang, L. Antibacterial Property of Graphene Quantum Dots (Both Source Material and Bacterial Shape Matter). ACS Appl. Mater. Interfaces 2016, 8, 20–25. [Google Scholar] [CrossRef]
- Anand, A.; Unnikrishnan, B.; Wei, S.C.; Chou, C.P.; Zhang, L.Z.; Huang, C.C. Graphene Oxide and Carbon Dots as Broad-Spectrum Antimicrobial Agents—A Mini Review. Nanoscale Horiz. 2019, 4, 117. [Google Scholar] [CrossRef]
- Rojas-Andrade, M.D.; Nguyen, T.A.; Mistler, W.P.; Armas, J.; Lu, J.E.; Roseman, G.; Hollingsworth, W.R.; Nichols, F.; Millhauser, G.L.; Ayzner, A.; et al. Antimicrobial Activity of Graphene Oxide Quantum Dots: Impacts of Chemical Reduction. Nanoscale Adv. 2020, 2, 1074. [Google Scholar] [CrossRef] [PubMed]
- Tu, Y.; Lv, M.; Xiu, P.; Huynh, T.; Zhang, M.; Castelli, M.; Liu, Z.; Huang, Q.; Fan, C.; Fang, H.; et al. Destructive Extraction of Phospholipids from Escherichia coli Membranes by Graphene Nanosheets. Nat. Nanotechnol. 2013, 8, 594–601. [Google Scholar] [CrossRef]
- Zou, X.; Zhang, L.; Wang, Z.; Luo, Y. Mechanisms of the Antimicrobial Activities of Graphene Materials. J. Am. Chem. Soc. 2016, 138, 2064–2077. [Google Scholar] [CrossRef]
- Dallavalle, M.; Calvaresi, M.; Bottoni, A.; Melle-Franco, M.; Zerbetto, F. Graphene Can Wreak Havoc with Cell Membranes. ACS Appl. Mater. Interfaces 2015, 7, 4406–4414. [Google Scholar] [CrossRef]
- Chen, Y.; Pandit, S.; Rahimi, S.; Mijakovic, I. Graphene Nanospikes Exert Bactericidal Effect through Mechanical Damage and Oxidative Stress. Carbon 2024, 218, 118740. [Google Scholar] [CrossRef]
- Liu, J.; Rojas-Andrade, M.D.; Chata, G.; Peng, Y.; Roseman, G.; Lu, J.-E.; Millhauser, G.L.; Saltikov, C.; Chen, S. Photo-Enhanced Antibacterial Activity of ZnO/Graphene Quantum Dot Nanocomposites. Nanoscale 2018, 10, 158. [Google Scholar] [CrossRef] [PubMed]
- Qian, Y.; Wang, J.; Geng, X.; Jia, B.; Wang, L.; Li, Y.-Q.; Geng, B.; Huan, W. Graphene Quantum Dots Nanoantibiotic-Sensitized TiO2-x Heterojunctions for Sonodynamic-Nanocatalytic Therapy of Multidrug-Resistant Bacterial Infections. Adv. Healthcare Mater. 2024, 13, 2400659. [Google Scholar] [CrossRef]
- Lei, Y.; Yang, C.; Hou, J.; Wang, F.; Min, S.; Ma, X.; Jin, Z.; Xu, J.; Lu, G.; Huang, K.-W. Strongly Coupled CdS/Graphene Quantum Dot Nanohybrids for Highly Efficient Photocatalytic Hydrogen Evolution: Unraveling the Essential Roles of Graphene Quantum Dots. Appl. Catal. B 2017, 216, 59–69. [Google Scholar] [CrossRef]
- Tang, Y.; Zhang, Y.; Deng, J.; Wei, J.; Tam, H.L.; Chandran, B.K.; Dong, Z.; Chen, Z.; Chen, X. Mechanical Force-Driven Growth of Elongated Bending TiO2-Based Nanotubular Materials for Ultrafast Rechargeable Lithium-Ion Batteries. Adv. Mater. 2014, 26, 6111–6118. [Google Scholar] [CrossRef]
- Shen, S.; Wang, C.; Sun, M.; Jia, M.; Tang, Z.; Yang, J. Free-Standing Sodium Titanate Ultralong Nanotube Membrane with Oil-Water Separation, Self-Cleaning, and Photocatalysis Properties. Nanoscale Res. Lett. 2020, 15, 22. [Google Scholar] [CrossRef]
- Xiong, G.; Shen, S.; Xiao, S.; Cai, C.; Zhang, P.; Tang, Z.; Li, J.; Yang, J. Well-Defined Z-Scheme Na2Ti3O7/Ag/CdS Multidimensional Heterojunctions with Enhanced H2 Production from Seawater under Visible Light. Int. J. Hydrogen Energy 2022, 47, 30503–30516. [Google Scholar] [CrossRef]
- GB/T 31402-2023; Measurement of Antibacterial Activity on Plastics and Other Non-Porous Surfaces. National Standard of the People’s Republic of China: Beijing, China, 2023.
- Zhang, Y.; Guo, L.; Yang, S. Three-Dimensional Spider-Web Architecture Assembled from Na2Ti3O7 Nanotubes as a High-Performance Anode for a Sodium-Ion Battery. Chem. Commun. 2014, 50, 14029–14032. [Google Scholar] [CrossRef]
- Yang, H.; Wang, P.; Wang, D.; Zhu, Y.; Wang, X. New Understanding on Photocatalytic Mechanism of Nitrogen-Doped Graphene Quantum Dots-Decorated BiVO4 Nanojunction Photocatalysts. ACS Omega 2017, 2, 3766–3773. [Google Scholar] [CrossRef]
- Ni, J.; Fu, S.; Wu, C.; Zhao, Y.; Maier, J.; Yu, Y.; Li, L. Superior Sodium Storage in Na2Ti3O7 Nanotube Arrays through Surface Engineering. Adv. Energy Mater. 2016, 6, 1502568. [Google Scholar] [CrossRef]
- Yan, X.; Sun, D.; Jiang, J.; Yan, W.; Jin, Y. Self-Assembled Twine-Like Na2Ti3O7 Nanostructure as Advanced Anode for Sodium-Ion Batteries. J. Alloys Compd. 2017, 697, 208–214. [Google Scholar] [CrossRef]
- Tomić, N.; Grujić-Brojčin, M.; Kremenović, A.; Novaković, M.; Lazović, V.; Šćepanović, M. From Mixed Brookite/Anatase TiO2 Nanopowder to Sodium Titanates: Insight into Morphology, Structure, and Photocatalytic Performance. Ceram. Int. 2024, 50, 51465. [Google Scholar] [CrossRef]
- Zhang, H.; Lv, X.; Li, Y.; Wang, Y.; Li, J. P25-Graphene Composite as a High-Performance Photocatalyst. ACS Nano 2010, 4, 380–386. [Google Scholar] [CrossRef]
- Li, G.; Sun, Y.; Zhang, Q.; Gao, Z.; Sun, W.; Zhou, X. Ag Quantum Dots Modified Hierarchically Porous and Defective TiO2 Nanoparticles for Improved Photocatalytic CO2 Reduction. Chem. Eng. J. 2021, 410, 128397. [Google Scholar] [CrossRef]
- Kong, P.; Tan, H.; Lei, T.; Wang, J.; Yan, W.; Wang, R.; Waclawik, E.R.; Zheng, Z.; Li, Z. Oxygen Vacancies Confined in Conjugated Polyimide for Promoted Visible-Light Photocatalytic Oxidative Coupling of Amines. Appl. Catal. B Environ. 2020, 272, 118964. [Google Scholar] [CrossRef]
- Rajender, G.; Kumar, J.; Giri, P.K. Interfacial Charge Transfer in Oxygen Deficient TiO2-Graphene Quantum Dot Hybrid and Its Influence on the Enhanced Visible Light Photocatalysis. Appl. Catal. B 2018, 224, 960. [Google Scholar] [CrossRef]
- Barai, H.R.; Rahman, M.M.; Joo, S.W. Template-Free Synthesis of Two-Dimensional Titania/Titanate Nanosheets as Electrodes for High-Performance Supercapacitor Applications. J. Power Sources 2017, 372, 227–234. [Google Scholar] [CrossRef]
- Li, P.; Li, J.; Feng, X.; Li, J.; Wang, B. Metal-Organic Frameworks with Photocatalytic Bactericidal Activity for Integrated Air Cleaning. Nat. Commun. 2019, 10, 2177. [Google Scholar] [CrossRef]
- Sun, L.; Du, T.; Hu, C.; Chen, J.; Lu, J.; Lu, Z.; Han, H. Antibacterial Activity of Graphene Oxide/g-C3N4 Composite through Photocatalytic Disinfection under Visible Light. ACS Sustainable Chem. Eng. 2017, 5, 8693–8701. [Google Scholar] [CrossRef]
- Xu, J.; Yan, X.; Qi, Y.; Fu, Y.; Wang, C.; Wang, L. Novel Phosphidated MoS2 Nanosheets Modified CdS Semiconductor for an Efficient Photocatalytic H2 Evolution. Chem. Eng. J. 2019, 375, 122053. [Google Scholar] [CrossRef]
- Liu, H.; Ma, S.; Shao, L.; Liu, H.; Gao, Q.; Li, B.; Fu, H.; Fu, S.; Ye, H.; Zhao, F.; et al. Defective Engineering in Graphitic Carbon Nitride Nanosheet for Efficient Photocatalytic Pathogenic Bacteria Disinfection. Appl. Catal. B 2020, 261, 118201. [Google Scholar] [CrossRef]
- Ren, Z.; Li, Y.; Ren, Q.; Zhou, H.; Zhang, X.; Wang, M.; Liu, X.; Pan, L. Heterojunction-Forming In-NiS/In2O3 Nanoparticles for the Photocatalytic Degradation of Tetracycline under Full Solar Spectrum Response. ACS Appl. Nano Mater. 2024, 7, 17424–17431. [Google Scholar] [CrossRef]
- Park, M.; Yoon, H.; Lee, J.; Kim, J.; Lee, J.; Lee, S.; Yoo, S.; Jeon, S. Efficient Solid-State Photoluminescence of Graphene Quantum Dots Embedded in Boron Oxynitride for AC-Electroluminescent Device. Adv. Mater. 2018, 30, 1802951. [Google Scholar] [CrossRef] [PubMed]
- Shao, H.; Heng, M.; Guo, J.; Yang, R.; Zhang, H.; Fan, J.; Li, G.; Miao, Y.; Xiao, S. 3D Interwoven SiC/g-C3N4 Structure for Superior Charge Separation and CO2 Photoreduction Performance. Langmuir 2025, 41, 1115–1125. [Google Scholar] [CrossRef]
- Zhang, Q.; Zhang, J.; Wang, X.; Li, L.; Li, Y.; Dai, W. In-N-In Sites Boosting Interfacial Charge Transfer in Carbon-Coated Hollow Tubular In2O3/ZnIn2S4 Heterostructure Derived from In-MOF for Enhanced Photocatalytic Hydrogen Evolution. ACS Catal. 2021, 11, 6276–6289. [Google Scholar] [CrossRef]
- Shen, S.; Chu, Y.; Xu, Y.; Liu, X.; Xiu, H.; Li, J.; Tang, Z.; Xu, J.; Xiao, S. Cu Doping Induced Synergistic Effect of S-Vacancies and S-Scheme Cu:Mn0.5Cd0.5S@CuS Heterojunction for Enhanced H2 Evolution from Photocatalytic Seawater Splitting. Int. J. Hydrogen Energy 2024, 62, 734–742. [Google Scholar] [CrossRef]
- Wang, Y.; Li, M.; Ding, M.; Li, Z.; Xu, R.; Jin, Z. Construction of Ag2Mo2O7-Loaded Graphdiyne S-Scheme Heterojunction for Photocatalytically Coupled Peroxydisulfate-Activated Degradation of 2,4-Dichlorophenol. Chem. Eng. J. 2025, 503, 158196. [Google Scholar] [CrossRef]
- Xu, Q.; Zhang, L.; Cheng, B.; Fan, J.; Yu, J. S-Scheme Heterojunction Photocatalyst. Chem 2020, 6, 1543–1559. [Google Scholar] [CrossRef]
- Fu, J.; Xu, Q.; Low, J.; Jiang, C.; Yu, J. Ultrathin 2D/2D WO3/g-C3N4 Step-Scheme H2-Production Photocatalyst. Appl. Catal. B 2019, 243, 556–565. [Google Scholar] [CrossRef]
- Jin, Z.; Li, H.; Li, J. Efficient Photocatalytic Hydrogen Evolution over Graphdiyne Boosted with a Cobalt Sulfide Formed S-Scheme Heterojunctions. Chin. J. Catal. 2022, 43, 303–315. [Google Scholar] [CrossRef]
- Cano, F.J.; Romero-Núñez, A.; Liu, H.; Reyes-Vallejo, O.; Ashok, A.; Velumani, S.; Kassiba, A. Variation in the Bandgap by Gradual Reduction of GOs with Different Oxidation Degrees: A DFT Analysis. Diamond Relat. Mater. 2023, 139, 110382. [Google Scholar] [CrossRef]
- Cano, F.J.; Coste, S.; Reyes-Vallejo, O.; Makowska-Janusik, M.; Velumani, S.; de la Luz Olvera, M.; Kassiba, A. Influence of GO Oxidation Degrees on the Organization and Physical Features of TiO2–GO-Based Nanocomposites for Water Dye Removal. Surf. Interfaces 2024, 46, 104004. [Google Scholar] [CrossRef]
- Zhang, C.; Gu, Y.; Teng, G.; Wang, L.; Jin, X.; Qiang, Z.; Ma, W. Fabrication of a Double-Shell Ag/AgCl/G-ZnFe2O4 Nanocube with Enhanced Light Absorption and Superior Photocatalytic Antibacterial Activity. ACS Appl. Mater. Interfaces 2020, 12, 29883–29898. [Google Scholar] [CrossRef]
- Xin, Q.; Shah, H.; Nawaz, A.; Xie, W.; Akram, M.Z.; Batool, A.; Tian, L.; Ullah Jan, S.; Boddula, R.; Guo, B.; et al. Antibacterial Carbon-Based Nanomaterials. Adv. Mater. 2019, 31, 1804838. [Google Scholar] [CrossRef] [PubMed]
- Yamaguchi, M.; Abe, H.; Ma, T.; Tadaki, D.; Hirano-Iwata, A.; Kanetaka, H.; Watanabe, Y.; Niwano, M. Bactericidal Activity of TiO2 Nanotube Thin Films on Si by Photocatalytic Generation of Active Oxygen Species. Langmuir 2020, 36, 12668–12677. [Google Scholar] [CrossRef] [PubMed]
- Mai, L.; Wang, D.; Zhang, S.; Xie, Y.; Huang, C.; Zhang, Z. Synthesis and Bactericidal Ability of Ag/TiO2 Composite Films Deposited on Titanium Plate. Appl. Surf. Sci. 2010, 257, 974–978. [Google Scholar] [CrossRef]
- Panda, A.B.; Gopikishan, S.; Mahapatra, S.K.; Barhai, P.K.; Das, A.K.; Banerjee, I. Bactericidal Efficiency of Nanostructured Al-O/Ti-O Composite Thin Films Prepared by Dual Magnetron Reactive Co-Sputtering Technique. Ceram. Int. 2014, 40, 4681–4690. [Google Scholar] [CrossRef]
- Hou, Y.; Li, X.; Zhao, Q.; Chen, G.; Raston, C.L. Role of Hydroxyl Radicals and Mechanism of Escherichia coli Inactivation on Ag/AgBr/TiO2 Nanotube Array Electrode under Visible Light Irradiation. Environ. Sci. Technol. 2012, 46, 4042–4050. [Google Scholar] [CrossRef]
- Liu, L.; Liu, Z.; Bai, H.; Sun, D.D. Concurrent Filtration and Solar Photocatalytic Disinfection/Degradation Using High-Performance Ag/TiO2 Nanofiber Membrane. Water Res. 2012, 46, 1101–1112. [Google Scholar] [CrossRef]

Disclaimer/Publisher’s Note: The statements, opinions and data contained in all publications are solely those of the individual author(s) and contributor(s) and not of MDPI and/or the editor(s). MDPI and/or the editor(s) disclaim responsibility for any injury to people or property resulting from any ideas, methods, instructions or products referred to in the content. |
© 2025 by the authors. Licensee MDPI, Basel, Switzerland. This article is an open access article distributed under the terms and conditions of the Creative Commons Attribution (CC BY) license (https://creativecommons.org/licenses/by/4.0/).
Share and Cite
Shen, S.; Wang, J.; Li, Y.; Liu, X.; Tang, Z.; Xiu, H.; Li, J.; Zhou, G. Enhanced Antibacterial Activity of Sodium Titanate/Graphene Quantum Dot Self-Supporting Membranes via Synergistic Photocatalysis and Physical Cutting. Materials 2025, 18, 1844. https://doi.org/10.3390/ma18081844
Shen S, Wang J, Li Y, Liu X, Tang Z, Xiu H, Li J, Zhou G. Enhanced Antibacterial Activity of Sodium Titanate/Graphene Quantum Dot Self-Supporting Membranes via Synergistic Photocatalysis and Physical Cutting. Materials. 2025; 18(8):1844. https://doi.org/10.3390/ma18081844
Chicago/Turabian StyleShen, Shuling, Ji Wang, Yaru Li, Xinjuan Liu, Zhihong Tang, Huixin Xiu, Jing Li, and Guanglei Zhou. 2025. "Enhanced Antibacterial Activity of Sodium Titanate/Graphene Quantum Dot Self-Supporting Membranes via Synergistic Photocatalysis and Physical Cutting" Materials 18, no. 8: 1844. https://doi.org/10.3390/ma18081844
APA StyleShen, S., Wang, J., Li, Y., Liu, X., Tang, Z., Xiu, H., Li, J., & Zhou, G. (2025). Enhanced Antibacterial Activity of Sodium Titanate/Graphene Quantum Dot Self-Supporting Membranes via Synergistic Photocatalysis and Physical Cutting. Materials, 18(8), 1844. https://doi.org/10.3390/ma18081844

